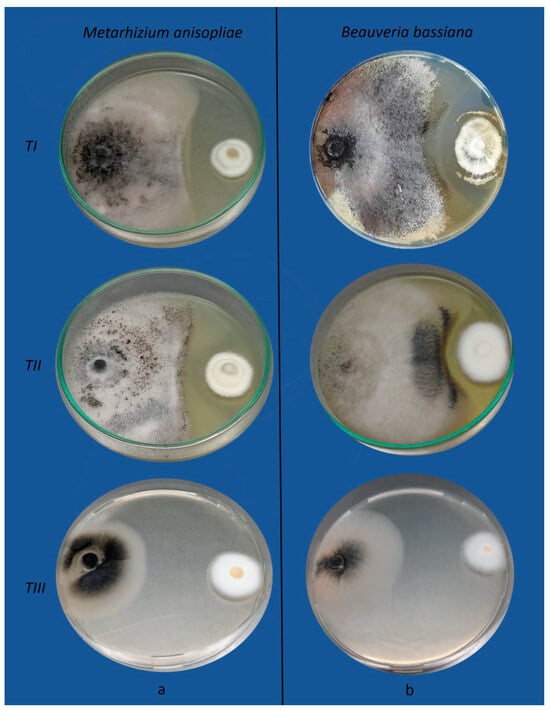

Abstract
Soybean (Glycine max) is one of the most important crops worldwide. This crop is prone to diseases caused by the phytopathogenic fungi Macrophomina phaseolina, Fusarium oxysporum, and the lepidopteran pest Rachiplusia nu. Biological control using entomopathogenic fungi is a sustainable alternative to chemical pesticides. In this study, we assessed the antifungal activity of Beauveria bassiana and Metarhizium anisopliae against phytopathogens and the pathogenicity of B. bassiana as an endophyte against R. nu. The antagonic activity of the fungal entomopathogens was evaluated in vitro by dual culture bioassays. The feeding preference of R. nu was evaluated in a “free choice” assay under laboratory conditions. Entomopathogenic fungi inhibited the mycelial growth of the phytopathogens. The best response in all cases was observed when the antagonists were placed in the culture medium two days before the pathogens. B. bassiana was the best antagonist of F. oxysporum, while both antagonists had similar inhibitory effects on M. phaseolina growth. Additionally, B. bassiana, when grown as an endophyte, reduced insects’ food preferences and decreased soybean consumption. Findings suggest that entomopathogenic fungi can fulfill multiple roles in the ecosystem. Therefore, the simultaneous expression of both properties should be considered for their application in integrated pest management programs.
1. Introduction
Soybean (Glycine max L. Merr) is a crop with significant economic importance and one of the most valuable commodities globally [1]. It is highly adaptable to various environmental conditions, making it a highly sought-after crop worldwide, with an annual planting area of 120 million hectares and 333 million tons of harvest [2,3]. Argentina is the third-largest soybean producer and the leading oil and meal exporter.
During their growth cycle, soybean plants are vulnerable to damage from various arthropod pests and pathogenic fungi, which can result in significant economic losses [4,5].
Soybean plants provide vital resources for herbivores; thus, some severe pests negatively impact the grain yield of the crop [6,7]. Rachiplusia nu (Guenée) (Lepidoptera: Noctuidae: Plusiinae) is a defoliating pest of soybean crops in Argentina, southern Brazil, Paraguay, Uruguay, and Bolivia [8]. Its populations have increased in recent years and caused problems in the early vegetative and grain-forming stages of soybean crops. The early-stage larvae of R. nu feed on the leaf parenchyma, most voraciously during their fifth larval instar. The larval feeding decreases the leaf area, causing a lower photosynthetic capacity, loss of stored leaf material, and shortening of the grain filling period [9,10].
On the other hand, Fusarium oxysporum (Ascomycota: Hypocreales) and Macrophomina phaseolina (Ascomycota: Botryosphaeriales) are fungal pathogens that heavily infect soybean crops and cause diseases that are transmitted through soil and seeds. More serious infections can reduce yield and seed quality and lead to pod abortion [5,11,12]. Fusarium oxysporum is one of the most destructive fungi that can cause root rot and wilt in soybeans [13]. Infected roots become shallow, fibrous, and eventually rot. Plants can wilt, especially in low humidity and high temperatures [14,15].
Macrophomina phaseolina is an economically important necrotrophic fungus that infects soybean crops at any growth stage, from seedlings to mature plants [16]. The disease is known as “charcoal rot” and causes root rot and rapid wilting, keeping the leaves attached [17]. Chemical insecticides and fungicides have become the control methods most widely used in agriculture against pest arthropods and severe fungal diseases that limit crop growth and yield [18]. However, although they have proven effective in various cases, they have also brought new and unforeseen issues, such as human toxicity and ecosystem imbalance due to the decrease in abundance and diversity of non-target organisms [8,9,19,20]. Consequently, the search for more targeted and environmentally friendly control methods is of particular interest [8,21]. The entomopathogenic fungi Beauveria bassiana (Ascomycota: Hypocreales) and Metarhizium anisopliae (Ascomycota: Hypocreales) are natural enemies of many insects and have been extensively studied for biological control [22,23,24]. As endophytes, they have been inoculated in different plant species through various techniques [25]. Several genera of entomopathogenic fungi have been shown to protect plants against fungal pathogens. Studies have demonstrated that B. bassiana is effective against Fusarium species [14,26,27,28] and M. anisopliae against F. oxysporum [27,29] and F. graminearum [30]. Nevertheless, the antagonistic effects of M. anisopliae and B. bassiana against M. phaseolina have not been previously evaluated. On the other hand, previous studies have shown the capacity of M. anisopliae and B. bassiana to establish as endophytes in soybean plants and control insect pests [31,32].
Our study aimed to evaluate the antifungal activity of two entomopathogenic fungi, B. bassiana and M. anisopliae, against F. oxysporum and M. phaseolina. We also examined the endophytic capacity of B. bassiana for controlling R. nu to comprehensively determine their ability as dual biological controllers of pest insects and phytopathogenic fungi.
2. Material and Methods
Beauveria bassiana LPSc 1098 (accession number KT163259) was isolated from Triatoma infestans (Hemiptera: Reduviidae) from Chaco province, Argentina, and Metarhizium anisopliae LPSc 907 (accession number KJ772494) was isolated from Hemiptera: Cercopidae from Buenos Aires province, Argentina. Both were obtained from the culture collection of the “Instituto de Botánica Carlos Spegazzini” (LPSc). Fusarium oxysporum LPSc 1191 (accession number KF753954) and Macrophomina phaseolina LPSc 1185 (accession number KF753945) were isolated as endophytes from soybean crops in the Pampean Region of Argentina. These strains were also deposited in the culture collection and identified morphologically and molecularly by Pelizza et al. [33] and Russo et al. [34].
All strains were grown on potato glucose agar (PDA: Britania S.A., Buenos Aires, Argentina) at 25 °C, 85% RH, for 7–10 days in darkness and stored at 4 °C until use.
2.1. Bioassay I: In Vitro Antagonism (Dual Culture Assays)
The antagonistic activity of M. anisopliae and B. bassiana against F. oxysporum was evaluated in vitro. For each fungal isolate, mycelium discs of 5mm were obtained from seven-day-old pure cultures grown on potato dextrose agar (PDA) in Petri dishes [35]. One fungal antagonist (M. anisopliae or B. bassiana) was tested with one fungal pathogen (F. oxysporum or M. phaseolina) by inoculating the antagonist and pathogen onto opposite sides of 90-mm Petri dishes with 15 mL of PDA. Three treatments were used [36]: (a) treatment I: pathogens and antagonists were inoculated simultaneously; (b) treatment II: the pathogens were inoculated two days before the antagonists; and (c) treatment III: the antagonists were inoculated two days before the pathogens. Control plates contained only the antagonist or pathogen mycelial disc to check growth without interactions. The plates were incubated at 24 °C, 85% RH, in darkness for ten days [29], and the radial growth of the pathogens was measured. All the experiments were carried out in five replicates and repeated twice.
The radial growth percentage inhibition of the phytopathogenic fungi compared to control growth was calculated using the formula according to Barra-Bucarei et al. [19]:
[(R1 − R2)/R1] × 100
R1: radius of the pathogen colony in the control;
R2: radius of the pathogen colony in the interaction.
2.2. Bioassay II: Consumption and Feeding Preference
2.2.1. Insect Breeding
Rachiplusia nu was artificially reared in chambers maintained under controlled conditions of temperature (25 ± 2 °C), relative humidity (70–75%), and photoperiod (14:10 h L:D) at the “Instituto de Botánica Carlos Spegazzini” following Barrionuevo et al. [37]. The artificial diet used to feed the insects was based on Osores et al. [38]. To start the colony, the eggs were obtained from AgIdea S.A. (www.agidea.com.ar, accessed on 20 November 2022) [39] to avoid contamination by field insects.
2.2.2. Obtaining and Inoculating Soybean Plants with B. bassiana
Soybean seeds of the DM 3810 variety (DM Catalogo–DonMario Semillas) were used. The seeds were superficially sterilized and sown in 300 cm3 pots with a sterile substrate consisting of a mixture of soil, perlite, and vermiculite in equal parts (1:1:1), following Russo et al. [7]. The plants were inoculated using foliar spraying, the most effective technique for introducing these strains. Inoculation was performed when the plants were ten days old and had developed true leaves. A hand sprayer was used to spray the abaxial surface with 2 mL of conidial suspension at a concentration of 1 × 108 conidia/mL per plant [40]. Control plants were sprayed with 2 mL of a 0.01% (v/v) Tween 80 sterile water solution free of conidia [25,41,42]. Conidial concentration was determined using a Neubauer chamber. Conidial viability was assessed according to Greenfield et al. [43]. In all cases, the mean conidial viability was >95%.
2.2.3. Consumption and Feeding Preference
The “free choice method” was used to assess the feeding preference of R. nu [25]. Rachiplusia nu L2 larvae were fasted for 4 h and then individually placed in 9 cm diameter Petri dishes with moistened filter paper. Soybean leaf discs (3 cm diam.) previously weighed, one inoculated with B. bassiana (seven days post-inoculation) and another from control plants, were simultaneously offered to the larvae. The plates were incubated at 25 °C, 60% relative humidity, and a 14:10 h LD photoperiod for 24 h, allowing the larvae to choose between both discs. Three repetitions of 30 individuals each were performed. After 24 h, the fresh weight of the uneaten disc was obtained, and the remains were oven-dried at 60 °C until a constant weight was obtained. The ingested food was obtained from the difference between the dry weight of the disc offered and the remaining material at the end of the experiment. The leaf’s initial dry weight was estimated from the initial fresh weight using a correction factor obtained from the average dry weight/fresh weight ratio of a sample of control leaves. Dry weights were used due to the great variability in the leaf water content. The difference in weight between the offered discs and the remaining material represented the consumption during the assay [44,45].
2.3. Data Analysis
The antagonistic effects of the entomopathogenic fungi B. bassiana and M. anisopliae on the growth of F. oxysporum and M. phaseolina were analyzed using a two-way analysis of variance (ANOVA) (independent variable: strains of entomopathogenic fungi and pairing method (treatments) and response variable: radial growth inhibition of each phytopathogen (%)). A Tukey test was performed to explore the differences between the groups (p < 0.05). The effects of the LPSc 1098 strain on the feeding preference of R. nu larvae were investigated using a T-test (p < 0.05). All statistical analyses were performed with Infostat [46].
3. Results
3.1. Bioassay I: Antagonistic Activity of Entomopathogenic Fungi
The two entomopathogenic fungi inhibited F. oxysporum and M. phaseolina mycelial growth in the dual culture assay. Each pathogenic fungus differed significantly between both antagonists and between treatments (Table 1).

Table 1.
Results of ANOVA for antagonist factor, treatment factor, and the interaction between both factors (antagonist × treatment).
In all treatments, control cultures of both pathogenic fungi completely colonized the Petri dishes after ten days (Figure 1).

Figure 1.
Radial growth of the phytopathogenic fungi Fusarium oxysporum (a) and Macrophomina phaseolina (b) in control plates.
However, in the presence of antagonists, the colony diameter of the pathogens significantly decreased between treatments. Figure 2 and Figure 3 show the effects of B. bassiana and M. anisopliae on F. oxysporum and M. phaseolina growth, respectively.

Figure 2.
Antagonistic effects of Metarhizium anisopliae (a) and Beauveria bassiana (b) towards Fusarium oxysporum by the dual culture method. TI: the pathogen and the antagonists were inoculated simultaneously; TII: the pathogen was inoculated two days before the antagonists; TIII: the antagonists were inoculated two days before the pathogen.
Figure 3.
Antagonistic effects of Metarhizium anisopliae (a) and Beauveria bassiana (b) towards Macrophomina phaseolina by the dual culture method. TI: the pathogen and the antagonists were inoculated simultaneously; TII: the pathogen was inoculated two days before the antagonists; TIII: the antagonists were inoculated two days before the pathogen.
Treatment III was the most effective in all cases; highly significant differences were found between treatment III and treatments I and II. Furthermore, treatments I and II did not differ significantly (Figure 4).

Figure 4.
Inhibition percentage of radial growth of F. oxysporum (a) and M. phaseolina (b) by the fungal entomopathogens B. bassiana and M. anisopliae in the dual plate assay. Results are expressed as mean values (±SEM). Bars with different letters differ significantly at p < 0.05 (Tukey multiple range test after two-way ANOVA).
In treatment III, B. bassiana was the most effective antagonist against F. oxysporum, with 64.18% inhibition, while M. anisopliae inhibited 57.5%. On the contrary, antagonist inhibition did not exceed 50% in treatments I and II (Figure 4a). On the other hand, both B. bassiana and M. anisopliae were equally effective in inhibiting M. phaseolina growth in treatment III without showing significant differences (62% and 63% inhibition, respectively) (Figure 4b). Furthermore, when the growth of M. phaseolina was evaluated in the presence of B. bassiana and M. anisopliae, no significant differences were found between treatments I and II (Figure 4b).
3.2. Bioassay II: Consumption and Feeding Preference
The foliar consumption of the L2 larvae of R. nu shows significant differences (T = 3.83, df = 58, p < 0.0008). Beauveria bassiana LPSc 1098 as an endophyte in soybean plants decreased insect feeding preference and soybean consumption.
Foliar consumption was lower in plants inoculated with the fungus (30–39 mg/insect) than in control plants (35–50 mg/insect), as shown in Figure 5. Thus, colonization and persistence of B. bassiana LPSc 1098 as an endophyte in soybean plants could decrease the feeding preference and, therefore, its consumption by the insect.

Figure 5.
Beauveria bassiana colonized (treated) and non-colonized (control) leaves consumed (mg/insect) by Rachiplusia nu second instar larvae. Bars indicate mean values (±SEM). Bars with different letters differ significantly at p < 0.05 (Student’s t test).
4. Discussion
Biological control of plant pathogens and insect pests is crucial to decrease reliance on chemical pesticides and fungicides and increase agricultural sustainability. In this study, we investigated the antimicrobial activity of the entomopathogenic fungi B. bassiana and M. anisopliae against two fungal pathogens of soybean plants, F. oxysporum and M. phaseolina. Also, we assessed the feeding preference of R. nu, a lepidopteran pest of soybean crops.
Some species of entomopathogenic fungi, such as B. bassiana, Metarhizium brunneum, M. anisopliae, Lecanicillium lecanii, and Isaria javanica, are effective in controlling certain phytopathogenic fungi and stramenopiles, including Rhizoctonia solani, Pythium myriotylum, Sphaerotheca fuliginea, Botrytis cinerea, Fusarium oxysporum, Colletotrichium, Phytophthora, and Plasmopara viticola [19,26,27,31,47,48,49,50,51]. As far as we are concerned, this is the first study to analyze the antagonistic effects of M. anisopliae and B. bassiana on M. phaseolina. Most control agents are only active against either insect pests or plant pathogens. However, our results indicate that B. bassiana exhibits a dual antagonistic effect. This is consistent with previous research, which has also observed the dual action of this fungus against Botrytis cinerea, Alternaria alternata, the aphid Macrosiphum euphorbiae [51], B. cinerea, and the aphid tomato pest Myzus persicae [52]. In all treatments, the antagonism of B. bassiana against F. oxysporum and M. phaseolina was effective. However, treatment III shows a better response, with an inhibition percentage of 64.18% and 62%, respectively. Culebro-Ricardi et al. [26] also observed a slower growth of F. oxysporum when B. bassiana was applied to the medium two days before the pathogen, reaching a 70% inhibition percentage, compared to simultaneous inoculation. Shternshis et al. [28] demonstrated that the antifungal activity of B. bassiana increased over time, as the diameter of the phytopathogen colony under the influence of B. bassiana decreased significantly. Jaber and Alananbeh [27] found that B. bassiana prevented the mycelial growth of three Fusarium species (F. oxysporum, F. culmorum, and F. moniliforme), with percentages lower than 62%. Our results also reveal that M. anisopliae behaved similarly to B. bassiana and responded better to F. oxysporum (57.5%) and M. phaseolina (63%) in treatment III. Likewise, previous studies have shown that M. brunneum prevented the mycelial growth of three Fusarium species (F. oxysporum, F. culmorum, and F. moniliforme), with percentages ranging between 48% and 57% [27]. On the other hand, Picardal et al. [29] observed that M. anisopliae moderately inhibited the in vitro radial growth of the pathogen (31.27%). Hao et al. [30] concluded that this fungus produces a clear inhibition zone in front of the F. graminearum colony, leading to observable deformation and branching of the pathogen hyphae.
Several authors have considered that entomopathogenic fungi inhibit pathogen growth and development due to resource competition, antibiosis, and parasitism. The production of volatile compounds and bioactive secondary metabolites with antimicrobial properties are the mechanisms of action involved in these activities [53]. Our results are consistent with Jaber and Alananbeh [27], who provided evidence of clear inhibition zones between antagonists and pathogens. Therefore, it is likely that these antagonism zones are caused by inhibitory metabolites (antibiosis) produced by fungi. Beauveria bassiana produces a variety of important metabolites, including bassianolide, bassianin, beauveriolide, bassiacridine, cyclosporine, oosporein, and beauvericin, the last two with antifungal activity. Metarhizium sp. can produce other secondary metabolites, such as destruxins, swainsonines, serinocyclins, and cytochalasins [54]. The inoculation and establishment of entomopathogenic fungi in plants emerge as alternative and promising avenues to overcome the constraints of environmental conditions in pest control [55].
Our findings reveal that when given the option to choose between plants inoculated and not inoculated with the entomopathogenic fungus B. bassiana, R. nu larvae had a greater preference for control plants. Previous studies [25,32,56] also showed that R. nu and Spodoptera frugiperda larvae consumed fewer plants when the entomopathogenic fungus was present as an endophyte. Similarly, Castillo López et al. [57] and Martinuz et al. [58] confirmed through preference tests that Aphis gossypii preferred to feed on uncolonized plants. Vianna et al. [59] did not observe significant differences between the consumption of inoculated and non-inoculated tobacco plants by adults of D. speciosa, contrary to previous findings. Our results indicate that when given a choice, larvae tend to choose uncolonized leaves over those colonized by B. bassiana (evidenced by the significant reduction in the larval-preferred leaf weight). As a result, the soybean colonization by B. bassiana negatively impacted R. nu feeding preferences. According to Ownley et al. [31] and Russo et al. [25], this could be attributed to the antiherbivore properties of B. bassiana’s secondary metabolites in plants.
5. Conclusions
Entomopathogenic fungi have shown promising results regarding their antifungal activity and antiherbivore effects. This study highlights the multiple ecological roles that these fungi can play, further supporting their potential as control agents. It is crucial to consider the simultaneous expression of these fungi’s insecticidal and antifungal properties when considering their application in integrated pest management programs, particularly within the framework of sustainable agriculture.
Author Contributions
M.L.R., S.A.P. and M.F.V. conceived and designed the research. M.L.R., N.F., A.C.S., J.M.d.A. and M.I.T. conducted experiments and analyzed data. M.L.R. and M.F.V. wrote the manuscript. All authors have read and agreed to the published version of the manuscript.
Funding
This study was partially supported by the Agencia Nacional de Promoción Científica y Tecnológica (PICT STAR-UP 2020-0008, PICT 2019-1569, PICT2021-0347, PICT2021-0056, PICT2021-00127, PICT2021-0072) and the Universidad Nacional de La Plata (UNLP 11/N 903).
Institutional Review Board Statement
Not applicable.
Informed Consent Statement
Not applicable.
Data Availability Statement
Data are contained within the article.
Conflicts of Interest
The authors declare no conflict of interest.
References
- SAGPyA, Secretaría de Agricultura, Ganadería, Pesca y Alimentos; Agricultura, Ministerio de Economía. 2023 Estimaciones Agrícolas; MAGyP: Buenos Aires, Argentina, 2023. [Google Scholar]
- FAO. El Estado Mundial de la Agricultura y la Alimentación; FAO: Rome, Italy, 2019. [Google Scholar]
- Hossain, M.M.; Yasmin, L.; Rubayet, M.T.; Akamatsu, H.; Yamanaka, N. A major variation in the virulence of the Asian soybean rust pathogen (Phakopsora pachyrhizi) in Bangladesh. P. Pathol. 2022, 71, 1355–1368. [Google Scholar] [CrossRef]
- Andrade, F.; Taboada, M.; Lema, D.; Maceira, N.; Echeverría, H.; Posse, G.; Gamundi, J.C. Los Desafíos de la Agricultura Argentina: Satisfacer las Futuras Demandas y Reducir el Impacto Ambiental; Ediciones INTA: Buenos Aires, Argentina, 2017; p. 120. [Google Scholar]
- John, R.P.; Tyagi, R.D.; Prévost, D.; Satinder, K.B.; Stéphan, P.; Surampalli, R.Y. Mycoparasitic Trichoderma viride as a biocontrol agent against Fusarium oxysporum f. sp. adzuki and Pythium arrhenomanes and as a growth promoter of soybean. Crop. Prot. 2010, 29, 1452–1459. [Google Scholar] [CrossRef]
- Caccia, M.G.; Del Valle, E.; Doucet, M.E.; Lax, P. Susceptibility of Spodoptera frugiperda and Helicoverpa gelotopoeon (Lepidoptera: Noctuidae) to the entomopathogenic nematode Steinernema diaprepesi (Rhabditida: Steiner nematidae) under laboratory conditions. Chil. J. Agr. Res. 2014, 74, 123–126. [Google Scholar] [CrossRef]
- Russo, M.L.; Pelizza, S.A.; Vianna, M.F.; Allegrucci, N.; Cabello, M.N.; Toledo, A.V.; Mourelos, C.; Scorsetti, A.C. Efect of endophytic entomopathogenic fungi on soybean Glycine max (L.) Merr. growth and yield. J. King. Saud. Univ. Sci. 2019, 31, 728–736. [Google Scholar] [CrossRef]
- Jakubowicz, V.; Taibo, C.B.; Sciocco-Cap, A.; Arneodo, J.D. Biological and molecular characterization of Rachiplusia nu single nucleopolyhedrovirus, a promising biocontrol agent against the South American soybean pest Rachiplusia nu. J. Invertebr. Pathol. 2019, 166, 107211. [Google Scholar] [CrossRef]
- Pelizza, S.A.; Schalamuk, S.; Simón, M.R.; Stenglein, S.A.; Pacheco-Marino, S.G.; Scorsetti, A.C. Compatibility of chemical insecticides and entomopathogenic fungi for control of soybean defoliating pest, Rachiplusia nu. Rev. Argent. Microbiol. 2018, 50, 189–201. [Google Scholar] [CrossRef] [PubMed]
- Rimoldi, F.; Fogel, M.N.; Schneider, M.I.; Ronco, A.E. Efectos indirectos de insecticidas convencionales y biorracionales sobre la alimentación de Rachiplusia nu (Lepidoptera: Noctuidae). Rev. Colomb. Entomol. 2015, 41, 48–57. [Google Scholar]
- Doubledee, M.D.; Rupe, J.C.; Rothrock, C.S.; Bajwa, S.G. Effect of root infection by Macrophomina phaseolina on stomatal conductance, canopy temperature and yield of soybean. Can. J. Plant. Pathol. 2018, 40, 272–283. [Google Scholar] [CrossRef]
- Li, Y.; Li, Z.; Chunling, W.; Xiaobing, G.; Wenbin, L. Antagonistic mechanism and control effect of Bacillus subtilis Y2 against Fusarium oxysporum causing soybean root rot. Afr. J. Microbiol. Res. 2013, 7, 652–656. [Google Scholar]
- Rahman, M.T.; Rubayet, M.T.; Khan, A.A.; Bhuiyan, M.K.A. 2020 Integrated management of Fusarium root rot and wilt disease of soybean caused by Fusarium oxysporum. Inter. J. Biosci. 2020, 17, 83–96. [Google Scholar]
- El Kichaoui, A.; Elnabris, K.; Shafie, A.; Fayyad, N.; Arafa, M.; El Hindi, M. Development of Beauveria bassiana-based bio-fungicide against Fusarium Wilt pathogens for Capsicum annuum, a Promising approach toward vital biocontrol industry in Gaza Strip. J. Nat. Stud. 2017, 25, 183–190. [Google Scholar]
- Li, N.; Alfiky, A.; Wang, W.; Islam, M.; Nourollahi, K.; Liu, X.; Kang, S. Volatile compound-mediated recognition and inhibition between Trichoderma biocontrol agents and Fusarium oxysporum. Front. Microb. 2018, 9, 2614. [Google Scholar] [CrossRef] [PubMed]
- Yasmin, H.; Naeem, S.; Bakhtawar, M.; Jabeen, Z.; Nosheen, A.; Naz, R.; Hassan, M.N. Halotolerant rhizobacteria Pseudomonas pseudoalcaligenes and Bacillus subtilis mediate systemic tolerance in hydroponically grown soybean (Glycine max L.) against salinity stress. PLoS ONE 2020, 15, e0231348. [Google Scholar] [CrossRef] [PubMed]
- Reznikov, S.; Vellicce, G.R.; Mengistu, A.; Arias, R.S.; Gonzalez, V.; Lisi, V.D.; Ploper, L.D. Disease incidence of charcoal rot (Macrophomina phaseolina) on soybean in north-western Argentina and genetic characteristics of the pathogen. Can. J. Plant Pathol. 2018, 40, 423–433. [Google Scholar] [CrossRef]
- Carmona, M.A. Enfermedades de fin de Ciclo y Mancha ojo de Rana en el Cultivo de Soja: Desarrollo y Validación de un Sistema de Puntuación y Determinación del Umbral de Control. Doctoral Thesis, Facultad de Ciencias Agrarias y Forestales, Buenos Aires, Argentina, 2014. [Google Scholar]
- Barra-Bucarei, L.; France Iglesias, A.; Gerding González, M.; Silva Aguayo, G.; Carrasco-Fernández, J.; Castro, J.F.; Ortiz Campos, J. Antifungal activity of Beauveria bassiana endophyte against Botrytis cinerea in two solanaceae crops. Microorganisms 2019, 8, 65. [Google Scholar] [CrossRef]
- Murúa, M.G.; Vera, M.A.; Herrero, M.I.; Fogliata, S.V.; Michel, A. Defoliation of soybean expressing Cry1Ac by lepidopteran pests. Insects 2018, 9, 93. [Google Scholar] [CrossRef]
- Haase, S.; Sciocco-Cap, A.; Romanowski, V. Baculovirus insecticides in Latin America: Historical overview, current status and future perspectives. Viruses 2015, 7, 2230–2267. [Google Scholar] [CrossRef]
- García, J.E.; Posadas, J.B.; Perticari, A.; Lecuona, R.E. Metarhizium anisopliae (Metschnikoff) Sorokin Promotes growth and has endophytic activity in tomato plants. Ad. Biol. Res. 2011, 5, 22–27. [Google Scholar]
- Shoukat, R.F.; Zafar, J.; Shakeel, M.; Zhang, Y.; Freed, S.; Xu, X.; Jin, F. Assessment of lethal, sublethal, and transgenerational effects of Beauveria bassiana on the demography of Aedes albopictus (Culicidae: Diptera). Insects 2020, 11, 178. [Google Scholar] [CrossRef]
- Zafar, J.; Shoukat, R.F.; Zhang, Y.; Freed, S.; Xu, X.; Jin, F. Metarhizium anisopliae challenges immunity and demography of Plutella xylostella. Insects 2020, 11, 694. [Google Scholar] [CrossRef]
- Russo, M.L.; Jaber, L.R.; Scorsetti, A.C.; Vianna, M.F.; Cabello, M.N.; Pelizza, S.A. Effect of entomopathogenic fungi introduced as corn endophytes on the development, reproduction, and food preference of the invasive fall armyworm Spodoptera frugiperda. J. Pest. Sci. 2021, 94, 859–870. [Google Scholar] [CrossRef]
- Culebro-Ricaldi, J.M.; Ruíz-Valdiviezo, V.M.; Rodríguez-Mendiola, M.A.; Ávila-Miranda, M.E.; Miceli, F.G.; Cruz-Rodríguez, R.I.; Montes-Molina, J.A. Antifungal properties of Beauveria bassiana strains against Fusarium oxysporum f. sp. lycopersici race 3 in tomato crop. J. Environ. Biol. 2017, 38, 821. [Google Scholar] [CrossRef]
- Jaber, L.; Alananbeh, K.M. Fungal entomopathogens as endophytes reduce several species of Fusarium causing crown and root rot in sweet pepper (Capsicum annuum L.). Biol. Control 2018, 126, 117–126. [Google Scholar] [CrossRef]
- Shternshis, M.V.; Shpatova, T.V.; Lelyak, A.A.; Drozdetskaya, E. In vitro antifungal activity of plant beneficial microorganisms against phytopathogenic fungi. Biosc. Biotech. Res. Asia 2014, 11, 1489–1497. [Google Scholar] [CrossRef]
- Picardal, J.P.; Tundag, E.D.; Picardal, M.T.; Gocong, G. Antagonistic Activity of Metarhizium anisopliae (Metschnikoff) Against Phytopathogenic Fusarium oxysporum f. sp. cubense (Schlecht.) as a biological control. J. Higher Educ. 2019, 13, 25–33. [Google Scholar]
- Hao, Q.; Albaghdady, D.M.; Xiao, Y.; Xiao, X.; Mo, C.; Tian, T.; Wang, G. Endophytic Metarhizium anisopliae is a potential biocontrol agent against wheat Fusarium head blight caused by Fusarium graminearum. J. Plant Pathol. 2021, 103, 875–885. [Google Scholar] [CrossRef]
- Ownley, B.H.; Gwinn, K.D.; Vega, F.E. Endophytic fungal entomopathogens with activity against plant pathogens: Ecology and evolution. BioControl 2010, 55, 113–128. [Google Scholar] [CrossRef]
- Russo, M.L.; Scorsetti, A.C.; Vianna, M.F.; Allegrucci, N.; Ferreri, N.A.; Cabello, M.N.; Pelizza, S.A. Effects of endophytic Beauveria bassiana (Ascomycota: Hypocreales) on biological, reproductive parameters and food preference of the soybean pest Helicoverpa gelotopoeon. J. King Saud Univ. Sci. 2019, 31, 1077–1082. [Google Scholar] [CrossRef]
- Pelizza, S.A.; Scorsetti, A.C.; Fogel, M.N.; Pacheco-Marino, S.G.; Stenglein, S.A.; Cabello, M.N.; Lange, C.E. Compatibility between entomopathogenic fungi and biorational insecticides in toxicity against Ronderosia bergi under laboratory conditions. BioControl 2015, 60, 81–91. [Google Scholar] [CrossRef]
- Russo, M.L.; Pelizza, S.A.; Cabello, M.N.; Stenglein, S.A.; Vianna, M.F.; Scorsetti, A.C. Endophytic fungi from selected varieties of soybean (Glycine max L. Merr.) and corn (Zea mays L.) grown in an agricultural area of Argentina. Rev. Argent. Microbiol. 2016, 48, 154–160. [Google Scholar] [CrossRef]
- Mascarin, G.M.; Marinho-Prado, J.S.; Assalin, M.R.; Martins, L.G.; Braga, E.S.; Tasic, L.; Lopes, R.B. Natural occurrence of Beauveria caledonica, pathogenicity to Cosmopolites sordidus and antifungal activity against Fusarium oxysporum f. sp. cubense. Pest Manag. Sci. 2022, 78, 4458–4470. [Google Scholar] [CrossRef] [PubMed]
- Sobowale, A.A.; Cardwell, F.C.; Odebode, A.C.; Bandyopadhyay, R.; Jonathan, S.G. Growth inhibition of Fusarium verticillioides (Sacc.) nirenberg by isolates of Trichoderma pseudokoningii strains from maize plant parts and its rhizosphere. J. Plant Prot. Res. 2005, 45, 249–265. [Google Scholar]
- Barrionuevo, M.J.; Murúa, M.G.; Goane, L.; Meagher, R.; Navarro, F. Life table studies of Rachiplusia nu (Guenee) and Chrysodeixis (Pseudoplusia includes (walker) (Lepidoptera: Noctuidae) on artificial diet. Fla. Entomol. 2012, 95, 944–951. [Google Scholar] [CrossRef]
- Osores, V.; Willink, E.; Costilla, M. Cría de Diatraea saccharalis F. en laboratorio. Bol EEAOC 1982, 139, 1–10. [Google Scholar]
- AgIdea. Available online: https://www.agidea.com.ar/ (accessed on 20 November 2022).
- Russo, M.L.; Pelizza, S.A.; Cabello, M.N.; Stenglein, S.A.; Scorsetti, A.C. Endophytic colonisation of tobacco, corn, wheat and soybeans by the fungal entomopathogen Beauveria bassiana (Ascomycota, Hypocreales). Biocontrol. Sci. Technol. 2015, 25, 475–480. [Google Scholar] [CrossRef]
- Qayyum, M.A.; Wakil, W.; Arif, M.J.; Sahi, S.T.; Dunlap, C.A. Infection of Helicoverpa armigera by endophytic Beauveria bassiana colonizing tomato plants. Biol. Control 2015, 90, 200–207. [Google Scholar] [CrossRef]
- Allegrucci, N.; Velazquez, M.S.; Russo, M.L.; Pérez, M.E.; Scorsetti, A.C. Endophytic colonisation of tomato by the entomopathogenic fungus Beauveria bassiana: The use of different inoculation techniques and their effects on the tomato leafminer Tuta absoluta (Lepidoptera: Gelechiidae). J. Plant Prot. Res. 2017, 54, 205–211. [Google Scholar] [CrossRef]
- Greenfield, M.; Gómez-Jiménez, M.I.; Ortiz, V.; Vega, F.E.; Kramer, M.; Parsa, S. Beauveria bassiana and Metarhizium anisopliae endophytically colonize cassava roots following soil drench inoculation. Biol. Control 2016, 95, 40–48. [Google Scholar] [CrossRef]
- Mariottini, Y.; de Wysiecki, M.L.; Lange, C.E. Postembryonic development and food consumption of Dichroplus elongatus Giglio-Tos and Dichroplus maculipennis (Blanchard)(Orhtoptera: Acrididae: Melanoplinae) under laboratory conditions. Neotrop. Entomol. 2011, 40, 190–196. [Google Scholar] [CrossRef]
- Sánchez, N.E.; De Wysiecki, M.L. A quantitative evaluation of feeding activity of the grasshopper Dichroplus pratensis Bruner (Orthoptera: Acrididae), in a natural grassland. Environ. Entomol. 1990, 19, 1392–1395. [Google Scholar] [CrossRef]
- InfoStat. Editorial Brujas, 1st ed.; InfoStat Group, Faculty of Agricultural Sciences, National University of Cordoba: Córdoba, Argentina, 2020. [Google Scholar]
- Aguilera-Sammaritano, J.; Caballero, J.; Deymié, M.; Rosa, M.; Vazquez, F.; Pappano, D.; González-Teuber, M. Dual effects of entomopathogenic fungi on control of the pest Lobesia botrana and the pathogenic fungus Eutypella microtheca on grapevine. Biol. Res. 2021, 54, 44. [Google Scholar] [CrossRef] [PubMed]
- Grabka, R.; d’Entremont, T.W.; Adams, S.J.; Walker, A.K.; Tanney, J.B.; Abbasi, P.A.; Ali, S. Fungal endophytes and their role in agricultural plant protection against pests and pathogens. Plants 2022, 11, 384. [Google Scholar] [CrossRef] [PubMed]
- Jaber, J.R. Grapevine leaf tissue colonization by the fungal entomopathogen Beauveria bassiana sl and its effect against downy mildew. BioControl 2015, 60, 103–112. [Google Scholar] [CrossRef]
- Kang, B.R.; Han, J.H.; Kim, J.J.; Kim, Y.C. Dual biocontrol potential of the entomopathogenic fungus, Isaria javanica, for both aphids and plant fungal pathogens. Mycobiology 2018, 46, 440–447. [Google Scholar] [CrossRef]
- Sinno, M.; Ranesi, M.; Di Lelio, I.; Iacomino, G.; Becchimanzi, A.; Barra, E.; Woo, S.L. Selection of endophytic Beauveria bassiana as a dual biocontrol agent of tomato pathogens and pests. Pathogens 2021, 10, 1242. [Google Scholar] [CrossRef]
- Yun, H.G.; Kim, D.J.; Gwak, W.S.; Shin, T.Y.; Woo, S.D. Entomopathogenic fungi as dual control agents against both the pest Myzus persicae and phytopathogen Botrytis cinerea. Mycobiology 2017, 45, 192–198. [Google Scholar] [CrossRef] [PubMed]
- Jaber, L.R.; Ownley, B.H. Can we use entomopathogenic fungi as endophytes for dual biological control of insect pests and plant pathogens? Biol. Control 2018, 116, 36–45. [Google Scholar] [CrossRef]
- Krasnoff, S.B.; Keresztes, I.; Gillilan, R.E.; Szebenyi, D.M.E.; Donzelli, B.G.G.; Churchill, A.C.L.; Gibson, D.M. Serinocyclins A and B, cyclic heptapeptides from Metarhizium anisopliae. J. Nat. Prod. 2007, 70, 1919–1924. [Google Scholar] [CrossRef]
- Dash, C.K.; Bamisile, B.S.; Keppanan, R.; Qasim, M.; Lin, Y.; Islam, S.U.; Wang, L. Endophytic entomopathogenic fungi enhance the growth of Phaseolus vulgaris L. (Fabaceae) and negatively affect the development and reproduction of Tetranychus urticae Koch (Acari: Tetranychidae). Microbial. Pathog. 2018, 125, 385–392. [Google Scholar] [CrossRef]
- Russo, M.L.; Scorsetti, A.C.; Vianna, M.F.; Cabello, M.; Ferreri, N.; Pelizza, S. Endophytic effects of Beauveria bassiana on corn (Zea mays) and its herbivore, Rachiplusia nu (Lepidoptera: Noctuidae). Insects 2019, 10, 110. [Google Scholar] [CrossRef]
- Castillo Lopez, D.; Zhu-Salzman, K.; Ek-Ramos, M.J.; Sword, G.A. The entomopathogenic fungal endophytes Purpureocillium lilacinum (formerly Paecilomyces lilacinus) and Beauveria bassiana negatively affect cotton aphid reproduction under both greenhouse and field conditions. PLoS ONE 2014, 9, e103891. [Google Scholar] [CrossRef] [PubMed]
- Martinuz, A.; Schouten, A.; Menjivar, R.D.; Sikora, R.A. Effectiveness of systemic resistance toward Aphis gossypii (Hom. Aphididae) as induced by combined applications of the endophytes Fusarium oxysporum Fo162 and Rhizobium etli G12. Biol. Control 2012, 62, 206–212. [Google Scholar] [CrossRef]
- Vianna, F.; Pelizza, S.; Russo, L.; Ferreri, N.; Scorsetti, A.C. Colonzation of Tobacco Plants by Fungal Entomopathogens and the Effect on Consumption over Diabrotica speciosa (Coleoptera: Chrysomelidae). J. Fungi 2021, 7, 1017. [Google Scholar] [CrossRef] [PubMed]
Disclaimer/Publisher’s Note: The statements, opinions and data contained in all publications are solely those of the individual author(s) and contributor(s) and not of MDPI and/or the editor(s). MDPI and/or the editor(s) disclaim responsibility for any injury to people or property resulting from any ideas, methods, instructions or products referred to in the content. |
© 2024 by the authors. Licensee MDPI, Basel, Switzerland. This article is an open access article distributed under the terms and conditions of the Creative Commons Attribution (CC BY) license (https://creativecommons.org/licenses/by/4.0/).